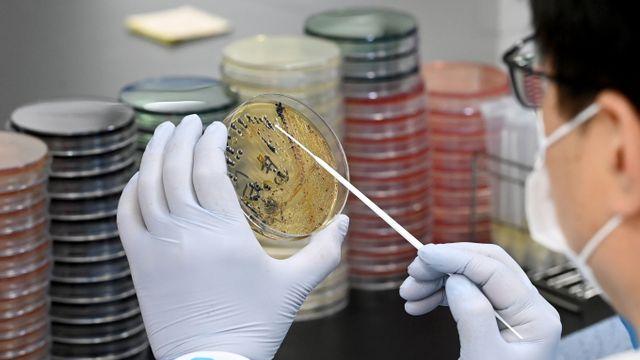

과속, 벨트,, 음주단속 안걸리는 꿀팁…
2023-07-22
주마레스에스에스아이코리아, 세계 1위 수영 고글 브랜드 조그스ZOGGS 브랜드 런칭

내일 날씨 전국 다시 장맛비…수도권 시간당 최대 60mm 폭우

가성비 쩌는 배민 리뷰 꿀팁

여름 집중호우 시기 식중독 주의보… 예방하는 방법은
“지방 소아청소년암환자의 응급상황은 어떻게 대처할 것인가”

국민 2명 중 1명 車 보유… 올 상반기 누적등록대수 2576만대

한국에 팁문화 정착을 위해 노력하는 기업

오늘의 날씨 이어지는 ‘찜통더위’···전국적 폭염특보

닥터마틴 싸게, 사는 꿀팁.






























